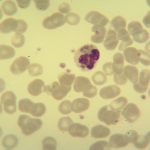
Foto da extensão sanguínea 1
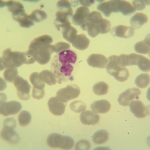
Foto da extensão sanguínea 2
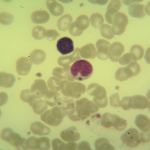
Foto da extensão sanguínea 3
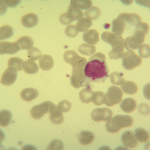
Foto da extensão sanguínea 4

Caso nº 2
Caso Clínico #4
Local: Curitiba-PR
Mês / Ano: Junho/2002
Assuntos relacionados: SÍNDROME DE CHEDIAK-HIGASHI. CRIANÇA. SEXO MASCULINO
Quadro Clínico
Paciente do sexo masculino com um ano e um mês.
O equipamento liberou os seguintes alarmes: neutropenia, linfocitose, monocitose, leucocitose, linfócitos atípicos?, blastos?, anisocitose e microcitose.
Com base nos dados clínicos e laboratoriais, propomos as seguintes questões para discussão do caso:
Com base nos alarmes do equipamento, resultado do hemograma e nas fotos da extensão sanguínea indique a hipótese diagnóstica laboratorial e faça uma breve discussão sobre sua escolha.
Referências Bibliográficas
SILVA, Paulo Henrique, et al. Hematologia Laboratorial: teoria e procedimentos. Porto Alegre, Ed. Artmed, 2016.
Dados Laboratoriais
1) Hemograma
| Eritrócitos | 4.590.000/uL |
| Hemoglobina | 11,2 g/dL |
| Volume globular | 33,3% |
| VCM | 72,5 fL |
| HCM | 24,4% |
| CHCM | 33,6% |
| RDW | 17,1% |
| Leucócitos | 13.660/uL |
| Eosinófilos | 5% |
| Linfócitos | 60% |
| Linfócitos atípicos | 1% |
| Monócitos | 12% |
| Bastonetes | 2% |
| Segmentados | 20% |
| Plaquetas | 348.000/uL |
Respostas da discussão
Hipótese diagnóstica laboratorial
Síndrome de Chediak-Higashi.
Discussão do caso laboratorial
O equipamento não conseguiu fazer a classificação das células devido à presença de granulações nos neutrófilos e nos linfócitos. Estas granulações são características da síndrome de Chediak-Higashi. Estes grânulos, que aparecem numerosos nos neutrófilos e únicos nos linfócitos, são grânulos lisossomais peroxidase positivos. Estes grânulos aparecem em todos os leucócitos (neutrófilos, eosinófilos, basófilos, linfócitos e monócitos). A presença destes grânulos faz o diagnóstico da síndrome de Chediak-Higashi. No laudo deve-se relatar a presença de grânulos nos leucócitos compatíveis com a síndrome de Chediak-Higashi.
Esta síndrome é rara e de herança autossômica recessiva, que se caracteriza pela presença de lisossomos gigantes nos leucócitos e em outras células do organismo. Os neutrófilos apresentam grânulos grandes resultantes da fusão de granulações primárias e secundárias, sendo estes grânulos mais proeminentes na medula óssea do que no sangue periférico devido a destruição intramedular de precursores mielóides. Em função desta destruição o paciente apresenta um número de neutrófilos que varia entre 500 a 2.000 neutrófilos/uL, e além da neutropenia os grânulos são deficientes em substâncias antimicrobianas, o que predispõe o paciente a infecções bacterianas de recorrência e muitas vezes fatais. Os monócitos, macrófagos, linfócitos e eosinófilos mostram grânulos gigantes no citoplasma e há perda de função destas células, perda da capacidade de fagocitose nos monócitos e macrófagos e perda da capacidade citotóxica dos linfócitos T e NK. As plaquetas apresentam incapacidade de armazenar ADP e serotonina, o que acarreta na deficiência da agregação plaquetária e predispõe o paciente a sangramentos. A forma homozigota apresenta um quadro clínico grave, praticamente incompatível com a vida devido à grande suscetibilidade às infecções bacterianas. Na forma heterozigota a presença destas granulações está associada, muitas vezes, à consanguinidade entre os pais do paciente além de albinismo parcial ou total, adeno-hepato-esplenomegalia e manifestações neurológicas variáveis. O diagnóstico desta síndrome é feito pela visualização de grânulos gigantes (grânulos lisossomais peroxidase positivo) nos leucócitos sanguíneos e nas células mielóides da medula óssea. É possível ainda fazer o diagnóstico pré-natal, já que os amniócitos e as células da vilosidade coriônica exibem os mesmos grânulos.